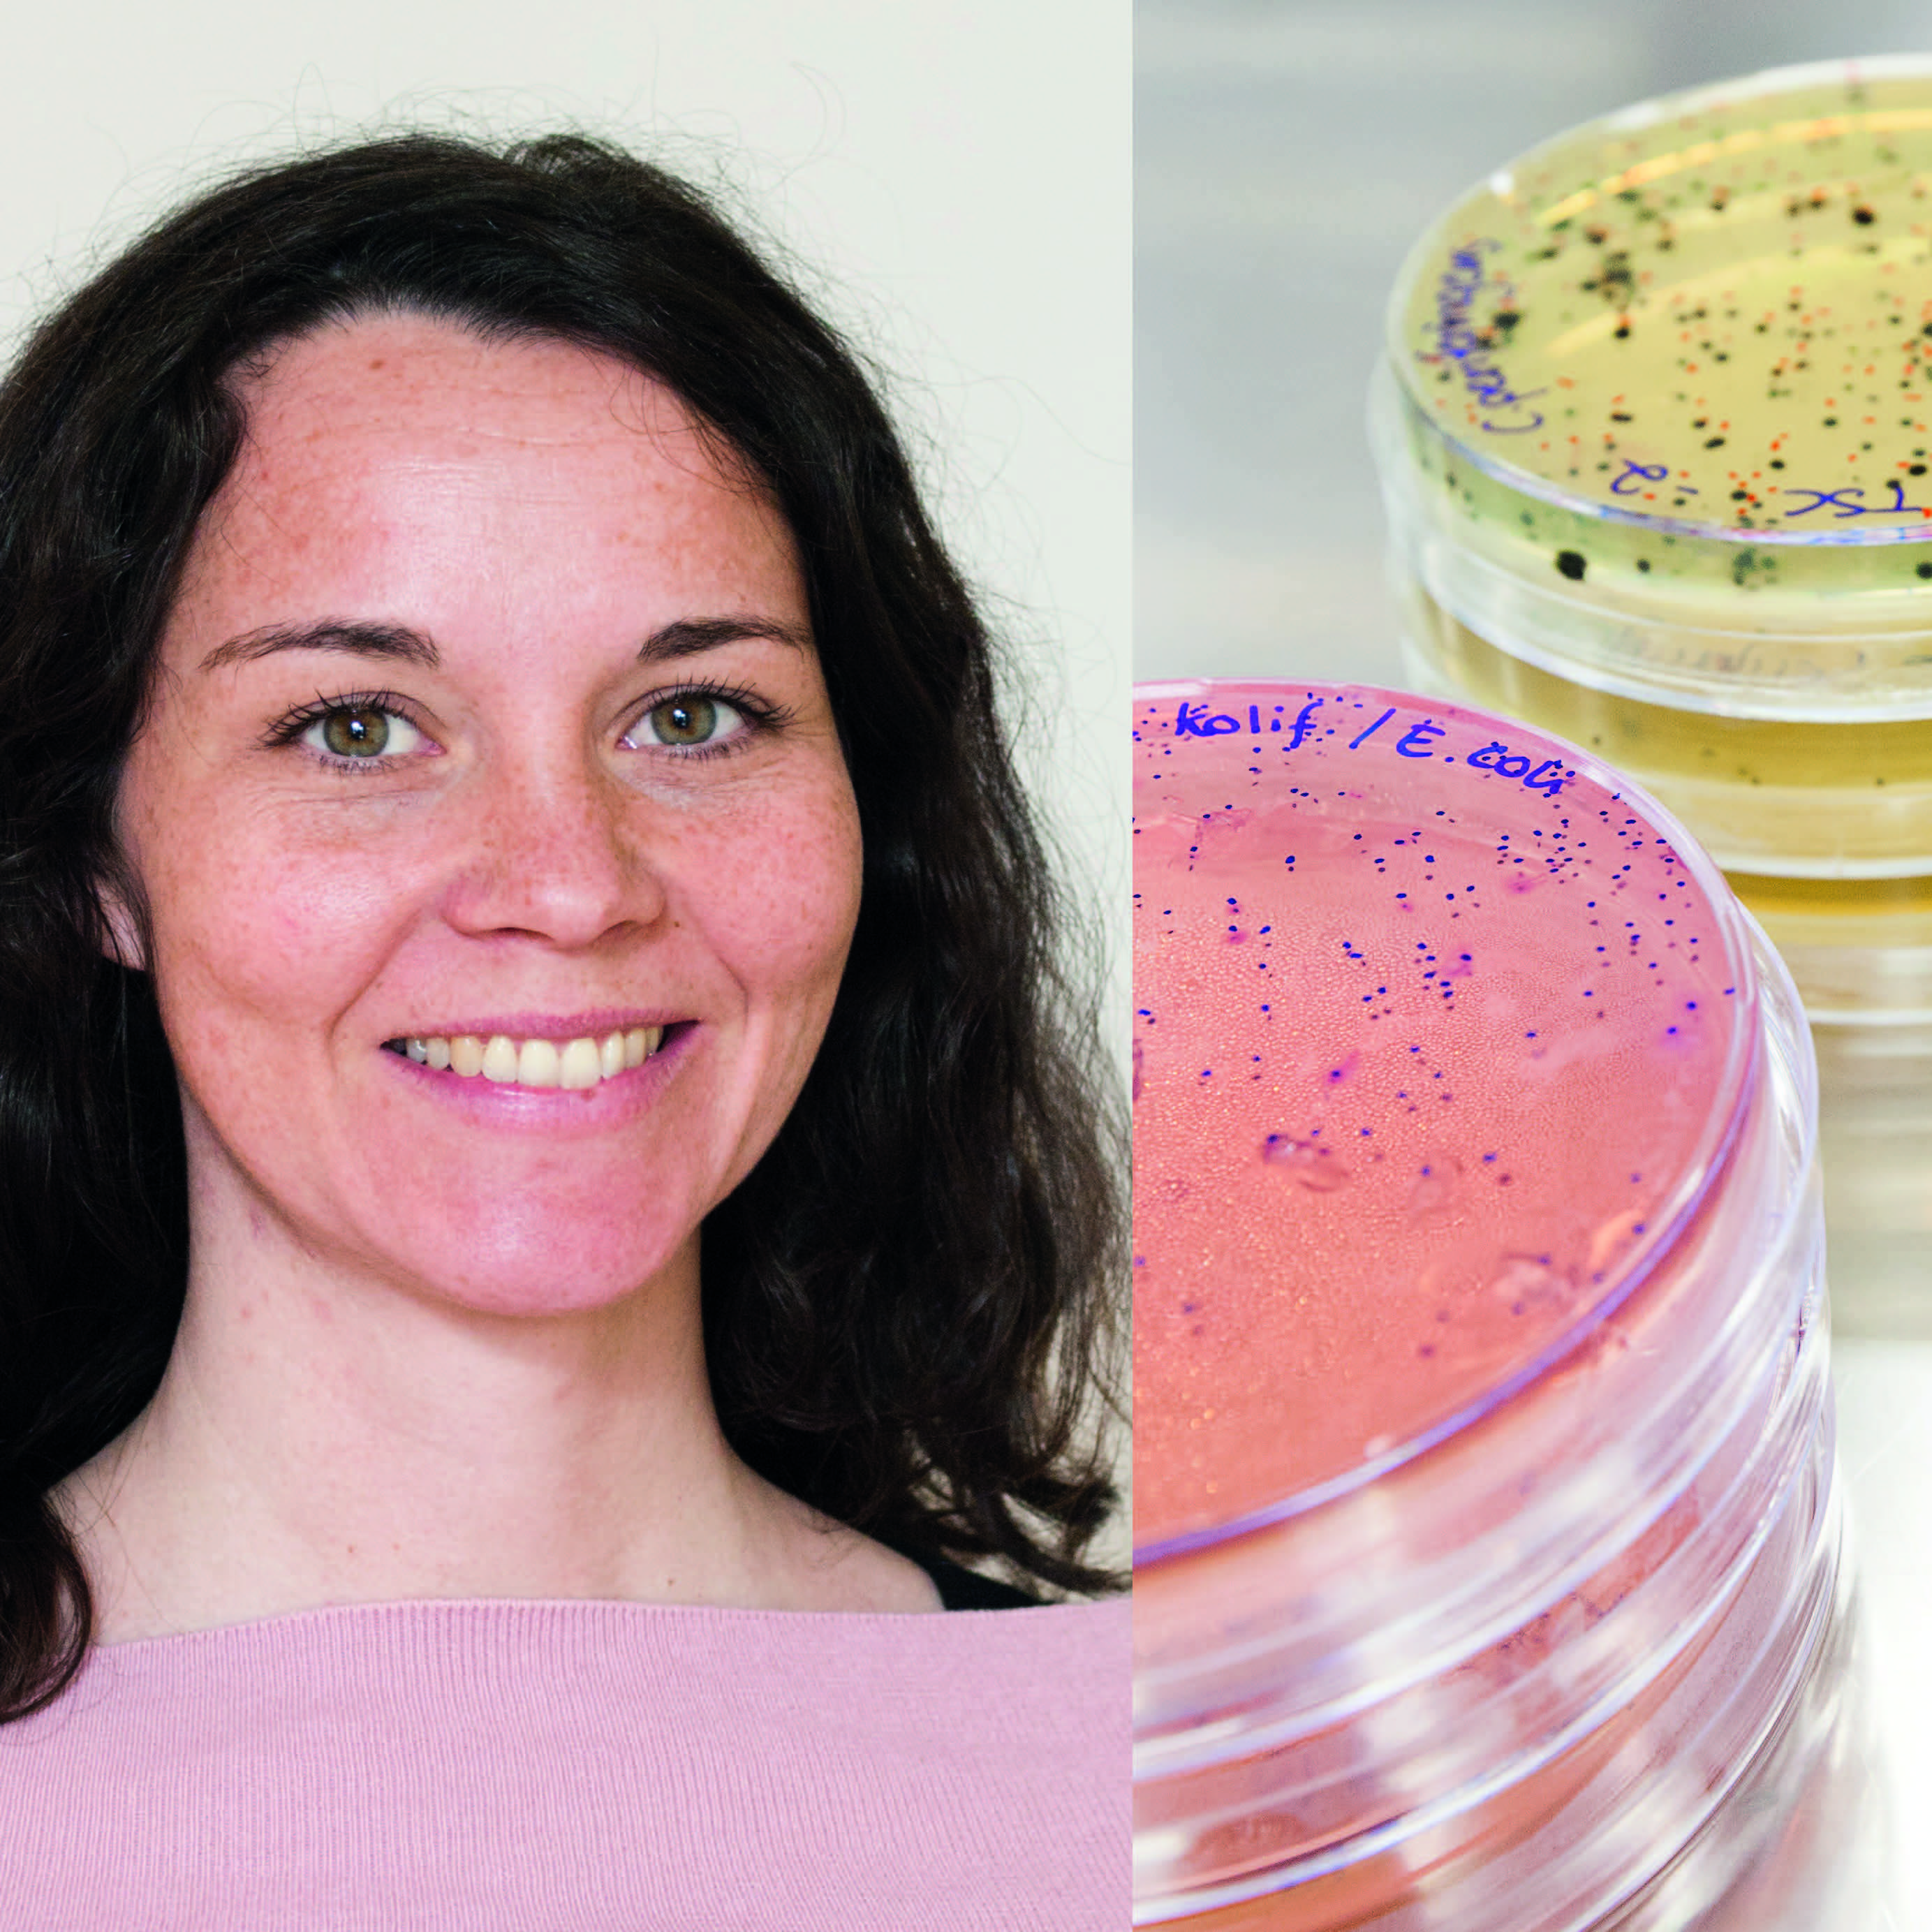
Woman and petri dishes

Kristina Osbjer has been working very closely with the Government in Cambodia in strengthening the overall animal health services including the efforts to work to combat antimicrobial resistance (AMR).
In 2015, WHO came up with the Global Action Plan on Antimicrobial Resistance. With this Cambodia saw the need of having a multisectoral action plan involving the animal, agricultural and environmental sector looking at the specific needs for Cambodia.
For the past three years, Kristina has been working to develop and implement the Multi-sectoral Action Plan on Antimicrobial Resistance in Cambodia.
In the interview, made by the AMR studio at the Uppsala Antibiotic Centre, Kristina talks about challenges and successes in conjunction with her work in Cambodia:
- The content of the plan very much depends on the local context, the local expertise, the current capacity, how much capacity building you have to put in, says Kristina.
- You also have to do a stakeholder mapping and analysis. What are the stakeholders in that specific country, where do we have experience laps and so on. It has to be written and guided by national experts and led by the government itself. This is a plan that is owned by its national government.
- It has been challenging to get the different sectors to work together. When I started to work in Cambodia in 2016 there was very little involvement of the agricultural sector and the environmental sector in the AMR work. So very much efforts were put into getting the different ministries to talk together, collaborate and to share data and information.
- Also like in many countries the human health side is very much advanced of the agricultural side and the environmental side and it is important to get the human side to see the benefits of collaborating with these two because there is not so much knowledge yet. They need to all see the benefits of collaborating.
- It has been fantastic to see during the past three years an enormous increase in understanding, in capacity, national laboratories, in testing and also in understanding where the needs are. We have seen a huge progress, now collaboration comes naturally!, Kristina says finally.
The interview was made by the AMR studio. a podcast from Uppsala Antibiotic Centre, dedicated to highlighting the multidisciplinary research on antimicrobial resistance that is happening around the world.